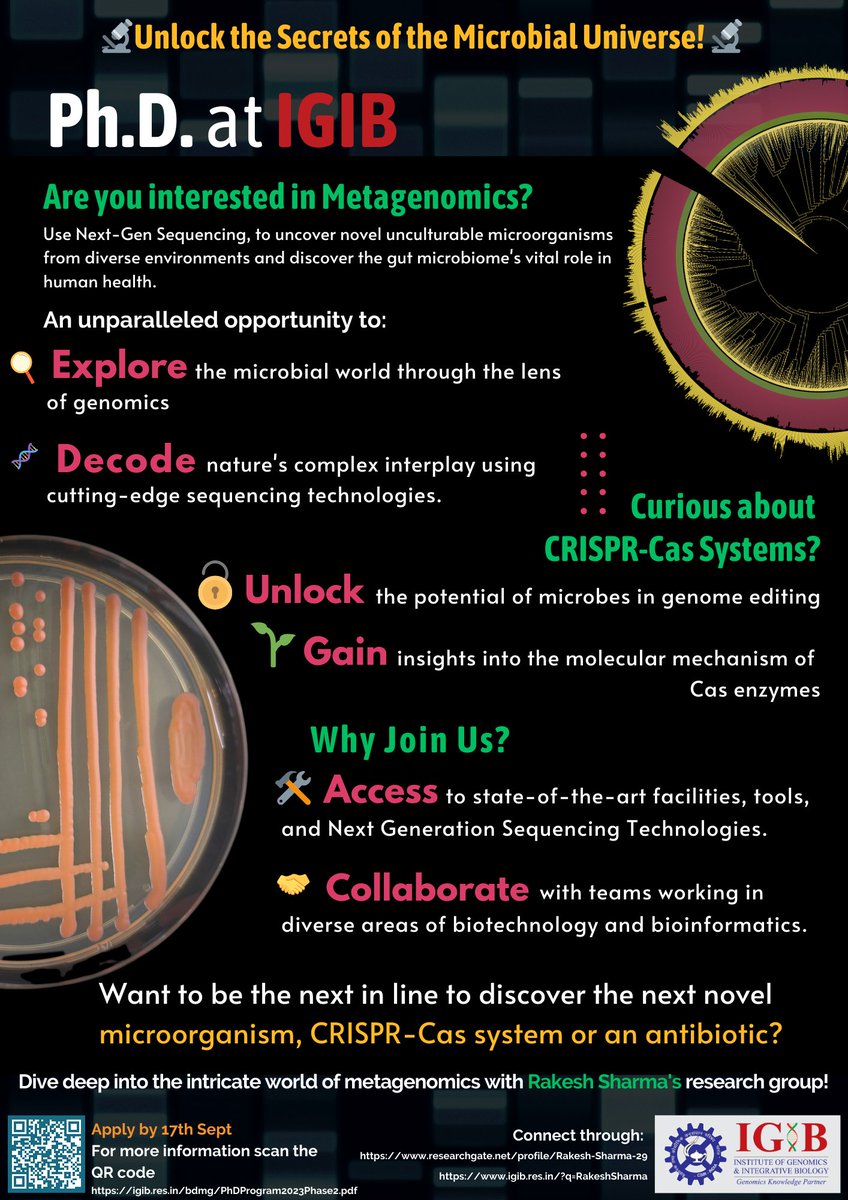
Vikas Hiremath tweet media

Vikas Hiremath retweetledi

Floor Microbiome of middle income houses in Delhi, India reveals presence of pathogenic bacteria, especially Escherichia coli, usually found in feces, on Living area floors and large number of clinically relevant AMR genes @ThisIsReckitt @ETEnvironment @ScienceNews @CSIR_IND
Rakesh Sharma@Rakesh_IGIB
Our research article on microbiome, pathogens and AMR in houses from Delhi, India. …ronmentalmicrobiome.biomedcentral.com/articles/10.11… @IGIBSocial @SaraswatiAwasth @vikasmh111 @sonamnain1
English